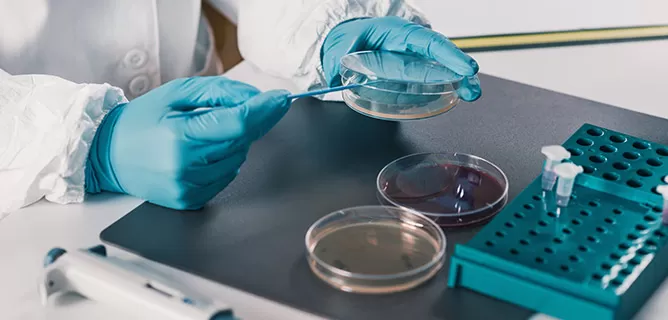
Vector Construction
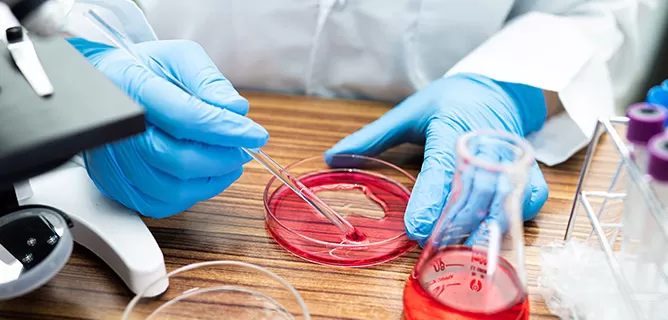
High-Throughput Cloning

Expression vectors for mammalian and yeast systems.
Automated library generation for screening campaigns.

Codon-optimized genes for higher yield.

Enable accurate monitoring of antibody library diversity.
Automated high-throughput cloning ensures reproducibility
Industrial-scale DNA synthesis supports large library projects
Reliable turnaround for time-sensitive screening studies
Seamless integration with downstream antibody development